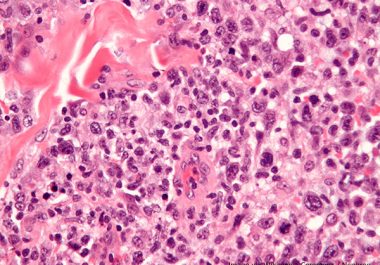

Genomic Profiling of Children May Lead to New Treatments
Pediatric patients whose cancer had relapsed were successfully matched to new gene-targeted therapies in large European trial, according to a study in the AACR journal Cancer Discovery.


Pediatric patients whose cancer had relapsed were successfully matched to new gene-targeted therapies in large European trial, according to a study in the AACR journal Cancer Discovery.
The FDA approved a molecularly targeted therapeutic to treat certain pediatric patients and young adults with anaplastic large-cell lymphoma, a rare form of non-Hodgkin lymphoma.